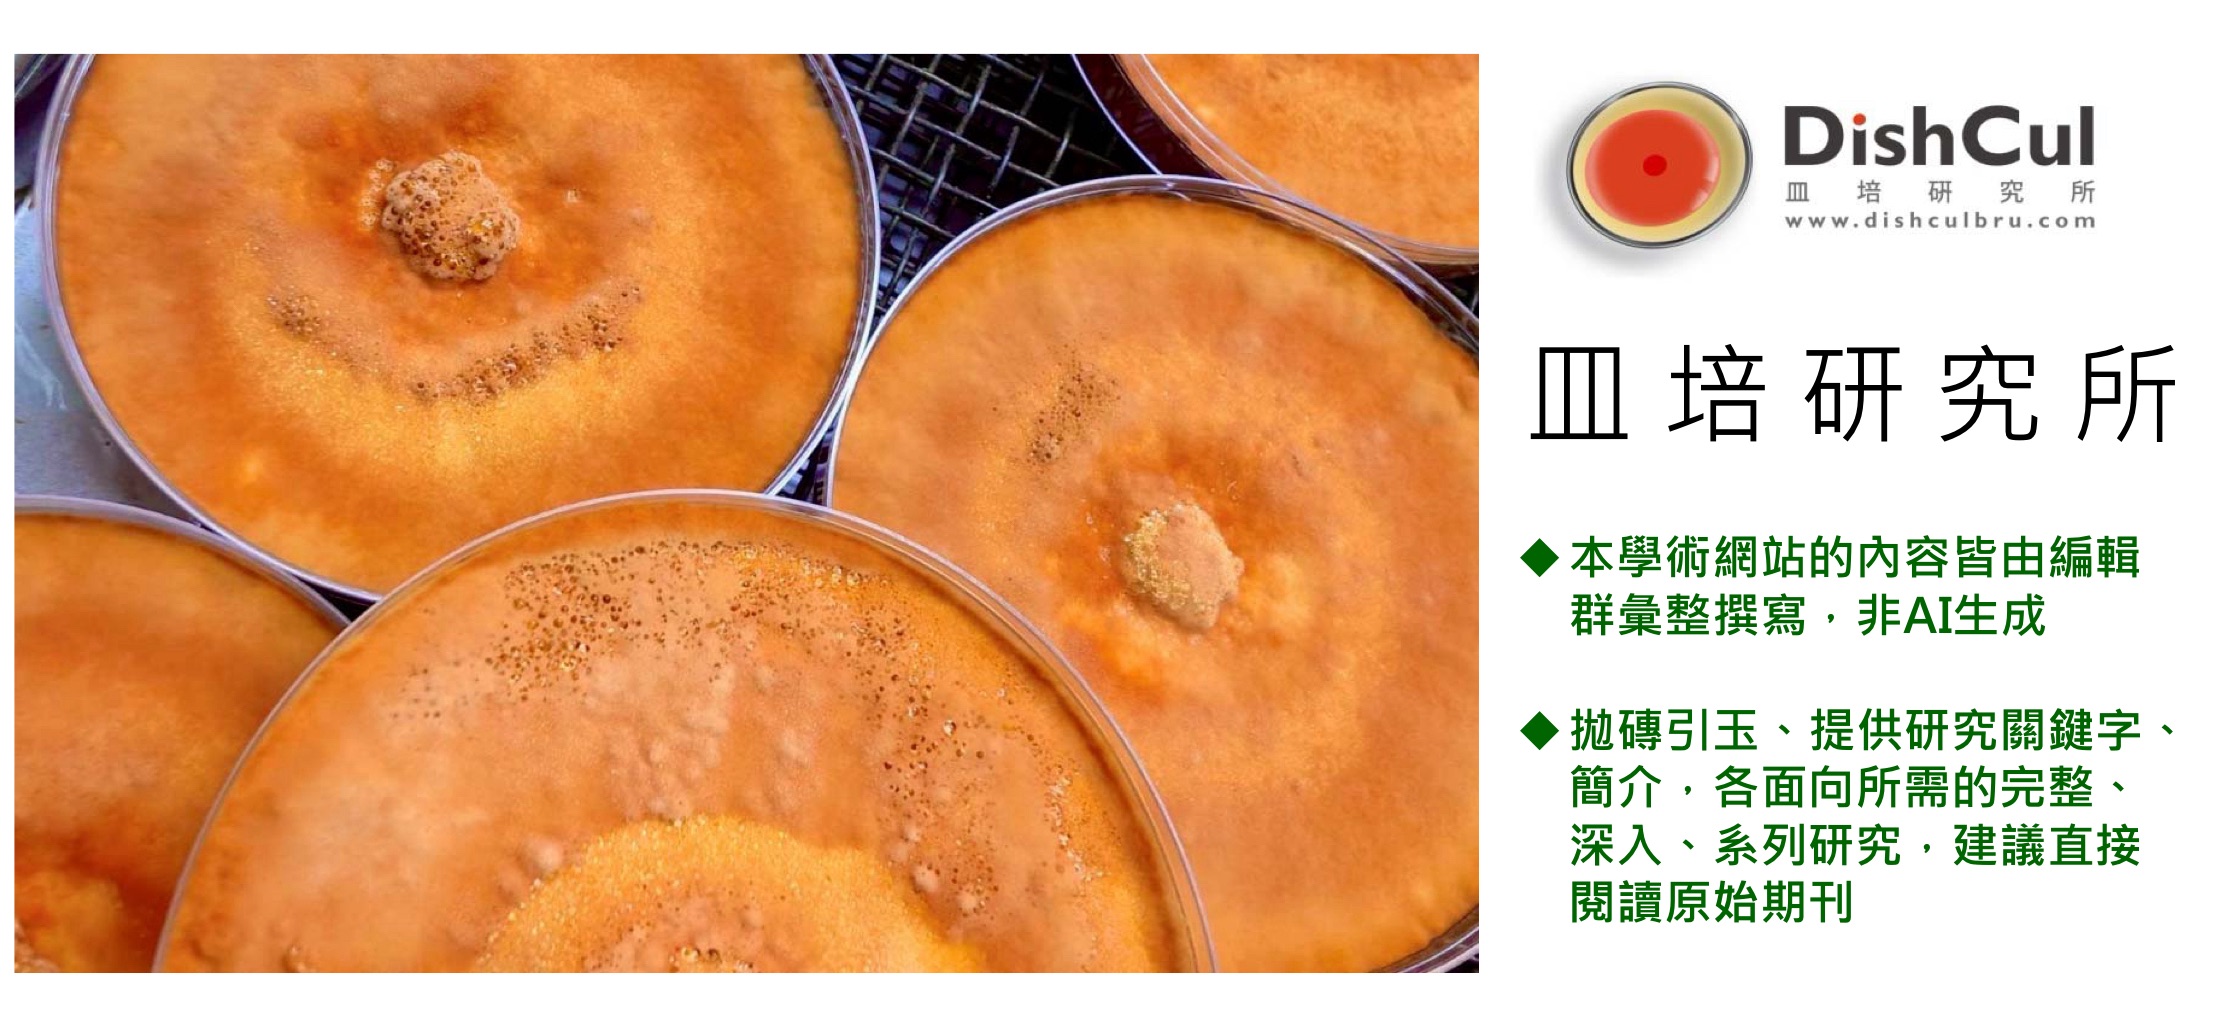
biomass phytochemical esg CDMO cancer anti-inflammatory antioxidant antrodia O2O OMO 植化素 皿培 牛樟芝 子實體 三萜類 樟芝酸 大健康 全齡健康 精準健康 癌症 抗發炎 抗氧化本土 植物新藥 新成分新藥 新藥標的 老藥新用 中草藥 藥食同源 生藥材
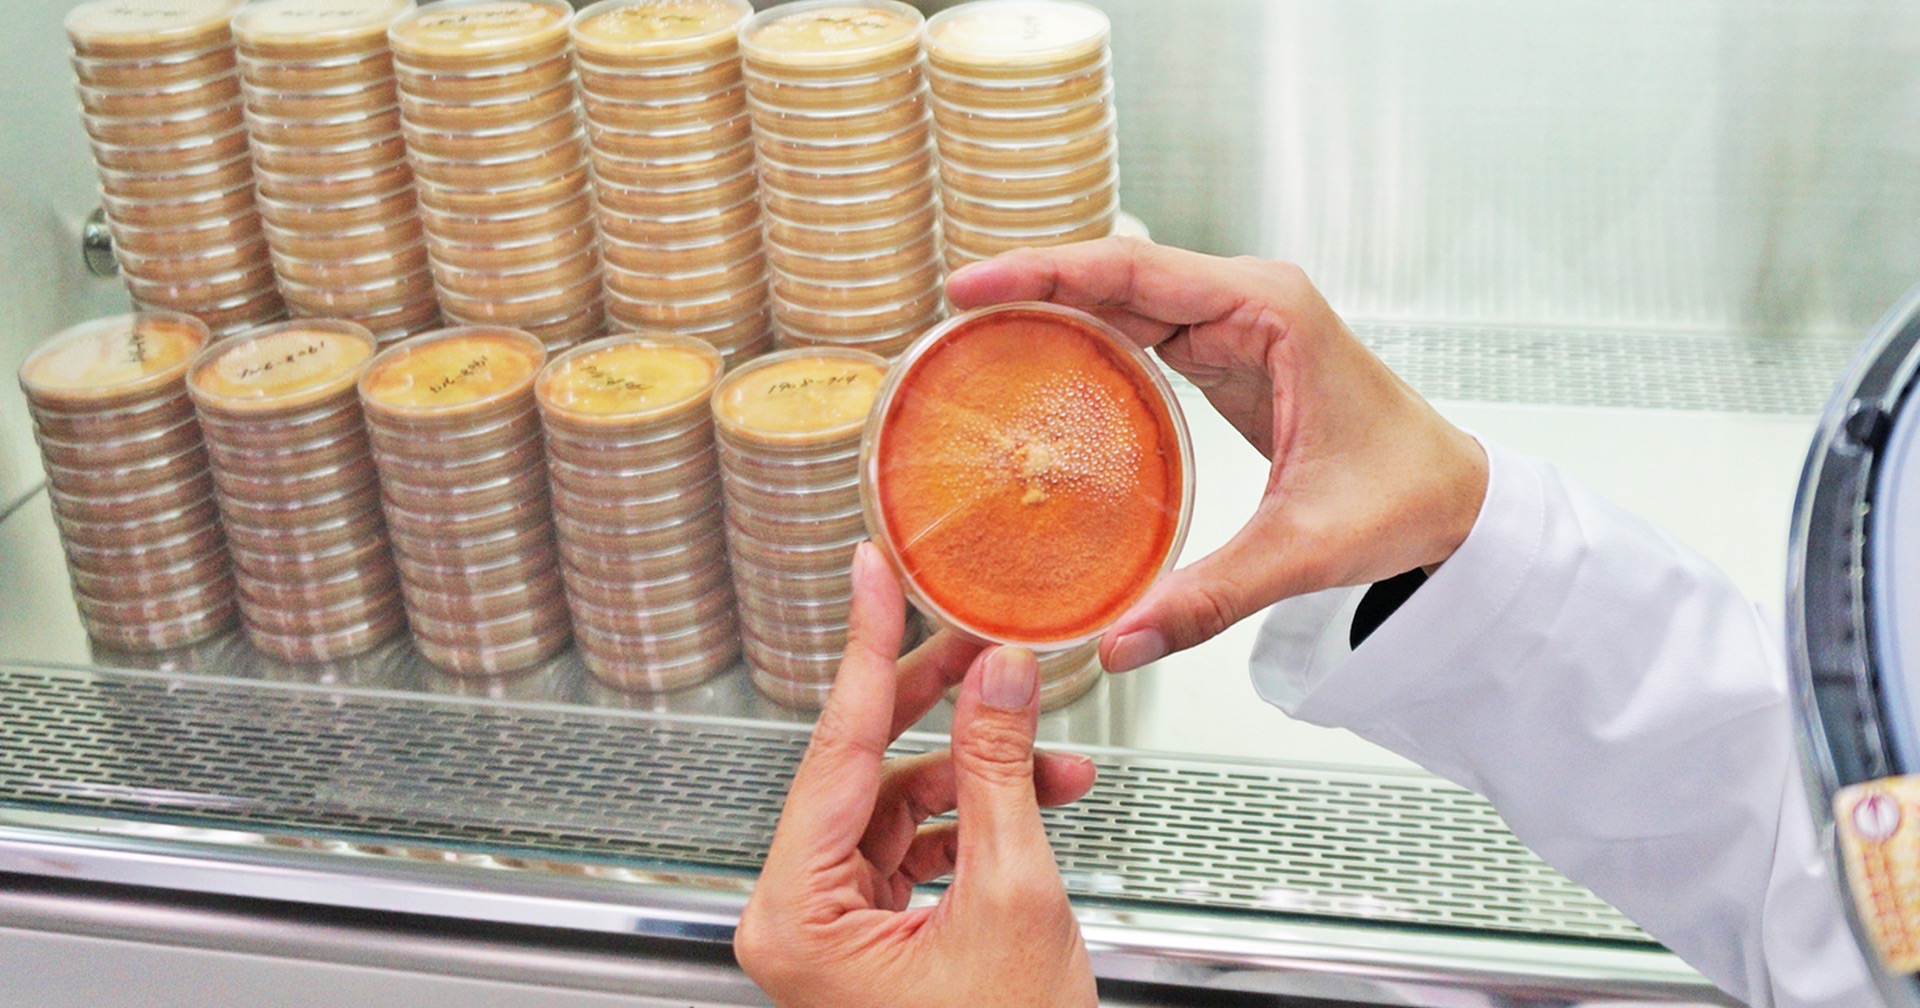
biomass phytochemical esg OMO antrodia 植化素 皿培 皿培研究所 牛樟芝 子實體 三萜類 樟芝酸 轉譯研究 新藥 老藥新用 中草藥 藥食同源 生藥

皿培研究所×植化素Biomass
皿培研究所,起心動念約在2014年,始於生技領域學術界&產業界的老師、學長姐、學弟妹交流聚會,希望以轉譯研究(Translational Research)模式將期刊論文之精華「化研為用」,除了科普叢書的實體撰寫與出版外,也嘗試線上網站的資訊分享,縮減紙本與數位化資訊的時間落差。
定位為「公評學術網站」,功能為「資訊分享平台」,實務為「找專家的專家」,以台灣特有食藥用真菌-牛樟芝的「皿培式培養」為主軸,致力於OMO線上線下虛實整合(Online Merge Offline),進行「多元化」生醫資訊的線上推播。
自2020年9月進行內容的汰舊換新、線上系統化,除了原有的牛樟芝內容外,逐步拓展至「生技產業-應用生技」的相關資訊匯整,以數位化方式呈現。
2024年7月進行網頁系統更新,優化觀看閱讀模式,強化圖檔、PDF資料的便利傳播。內容上更與時俱進,同時也以biomass生產植化素的生醫應用為主軸,因此網站名稱更新為:皿培研究所×植化素Biomass,網址更新為www.dishculbru.com

從皿培技術出發,展現「轉譯研究Translational Research」的「化研為用」
皿培技術biomass生產野生牛樟芝活性成分

野生牛樟芝的皿培技術規格化生產

皿培技術的野生牛樟芝中草藥現代化

科技還原天然,野生牛樟芝珍貴植化素phytochemical的生醫應用